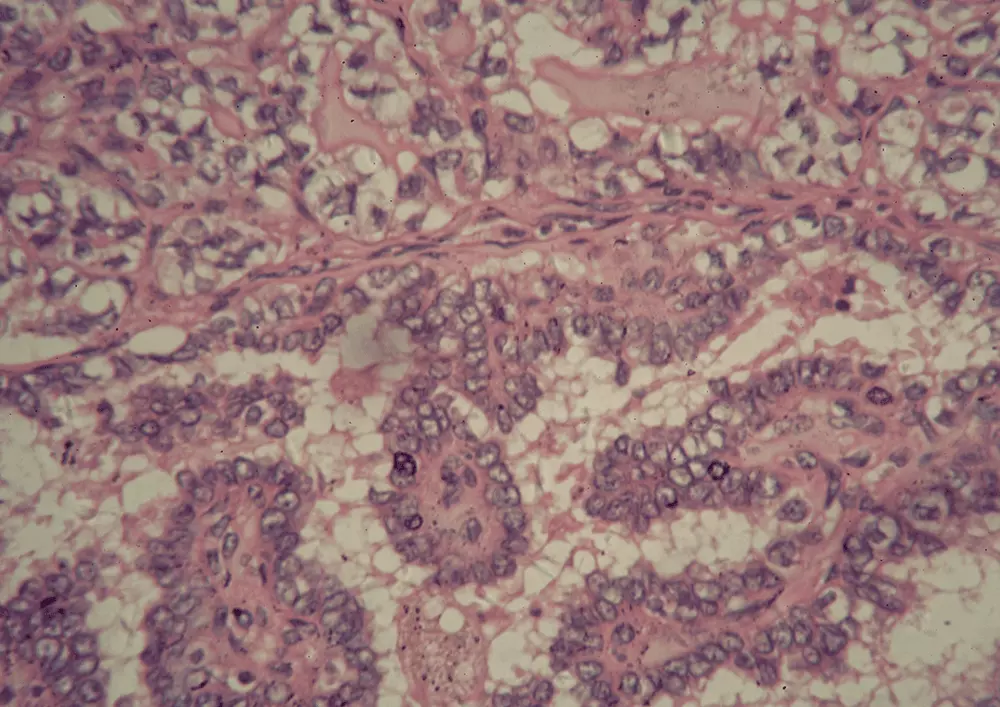

Sierpień 2017
Drodzy Czytelnicy,
przed nami jedenasty numer Body Challenge, dwumiesięcznika dedykowanego poszukującym wiedzy sportowcom, trenerom, instruktorom, pasjonatom i zawodowcom. W sierpniowym wydaniu odpowiemy m.in. na następujące pytania:
- Jak colostrum wzmacnia nieszczelne jelita?
- Bieganie – jak zacząć?
- Trening siłowy a budowanie masy mięśniowej. Jaki zakres powtórzeń warto zastosować?
- Inkontynencja w sporcie a ćwiczenia stabilizacyjne. Co należy o nich wiedzieć?
- Metylacja. Jak wpływa na nią gen MTHFR?
- Czy carb back – loading jest odpowiednią dietą dla osób początkujących?
- Jakie korzyści przynosi suplementacja selenu?
- Jakie błędy żywieniowe najczęściej popełniają ćwiczący na początku współpracy z trenerem personalnym?
Jak zacząć biegać?
Początki biegania teoretycznie nie powinny sprawić nam większego problemu. Czynność tą mamy bowiem zakodowaną ewolucyjnie. W praktyce jednak warto odpowiedzieć sobie na szereg pytań, wśród których najważniejsze brzmi: bieganie – jak zacząć? Jakub Krzyżak sugeruje dwa rozwiązania. Pierwszym z nich jest trening siłowy. Według tej idei bieganie dla początkujących powinien poprzedzić trening tworzony w oparciu o fundamentalne wzorce ruchów funkcjonalnych, pozwalających jednocześnie na dość prostą ocenę przykurczów mięśniowo-powięziowych. Druga opcja odpowiednia na początki biegania to marszobieg, czyli szybki marsz przeplatany truchtem lub biegiem. Pozwoli on naszemu ciału zaadaptować się do pracy kostno-stawowej i mięśniowej związanej z biegiem ciągłym. Znając więc odpowiedź na pytanie bieganie – jak zacząć, warto zastanowić się, w czym biega się najlepiej? Odpowiedź jest prosta: w wygodnych butach. Z czasem warto przejść na buty minimalistyczne, jednak zdecydowanie nie nadają się one na początek przygody. Skoro wiemy już w czym, należy zastanowić się również po czym biegać. Najlepsze na bieganie dla początkujących są leśne dukty, szutrowe drogi, równe łąki oraz inne plenery zapewniające dobrą amortyzację. Unikać warto z kolei betonu, asfaltu oraz plaży. Chcąc wiedzieć jak zacząć biegać, warto zdobyć szereg danych dotyczących stanu naszego ciała. Należą do nich m.in. EKG i USG. Dobrą praktyką jest także wizyta u fizjoterapeuty, który dokona przeglądu naszej motoryki. Jeśli chcecie poznać szczegółową odpowiedź na pytanie jak zacząć biegać, koniecznie sięgnijcie po najnowszy numer BC!
Inkontynencja a ćwiczenia stabilizacyjne
Ze względu na etiopatogenezę wyróżnia się wysiłkowe, naglące i mieszane nietrzymanie moczu. Najczęściej spotykany jest wariant wysiłkowy (WNT). Rozwiązaniem problemu mogą być ćwiczenia stabilizacyjne. Zalicza się do nich m.in. crocodile breathing oraz oddech przeponowy w pozycji dead bug i bird dog. Więcej informacji na temat ćwiczeń stabilizacyjnych w kontekście inkontynencji znajdziecie w artykule Zuzanny Sobczak.
Hipertrofia mięśniowa. Na jaki zakres powtórzeń warto postawić?
Hipertrofia mięśniowa, czyli wzrost mięśnia, jest składową wielu czynników. Możemy bowiem mówić m.in. o rozwoju objętościowym, siłowym i wytrzymałościowym. Zakres powtórzeń oraz wykorzystywany ciężar powinny zależeć od tego, jakiego rodzaju trening siłowy chcemy wykonać. Do wyboru mamy następujące cele: rozwój siły maksymalnej, rozwój siły i masy mięśniowej, rozwój masy mięśniowej oraz rozwój wytrzymałości siłowej. Wynika to z faktu, iż w naszym organizmie znajdują się trzy typy mięśni, a każdy z nich charakteryzuje się innym rodzajem preferowanej pracy. Jeśli interesuje nas budowanie masy mięśniowej, powinniśmy aktywować włókna typu II. Hipertrofia mięśniowa w ich przypadku zachodzi poprzez zastosowanie dużych ciężarów przy niskim zakresie powtórzeń. Więcej na temat treningu siłowego przeczytacie w artykule Pawła Głuchowskiego.
Nieszczelne jelita – objawy, diagnoza i leczenie
Najnowsze badania sugerują, że colostrum jest w stanie uszczelnić barierę jelito – krew nie pozwalając, by makroskładniki pokarmowe oraz inne cząsteczki trafiły do krwiobiegu. Jest to o tyle ważne, że nieszczelne jelita zaczynają być uważane za jedną z najważniejszych przyczyn wielu występujących obecnie chorób. Do czynników uszkadzających zaliczyć można m.in. używki, stres psychiczny oraz nadmierny stres fizyczny.
Nieszczelne jelita – objawy: zmiany skórne, problemy ze strony przewodu pokarmowego (biegunki, wzdęcia, zaparcia, bóle brzucha), migrena, zespół chronicznego zmęczenia, depresja, cukrzyca typu 2, nadciśnienie tętnicze, pogorszenie formy psychicznej i fizycznej, otyłość i nadwaga.
Nieszczelne jelita zdiagnozować można za pomocą zonuliny oraz stosunku laktulozy do mannitolu.
Do najpopularniejszych metod terapii zaliczyć można z kolei unikanie toksyn, zmniejszenie stanu zapalnego jelit oraz regenerację błony śluzowej.
Więcej informacji na temat nieszczelnych jelit oraz zbawiennych właściwości colostrum znajdziecie w artykule Jakuba Mauricza.
Carb back – loading jako dieta dla początkujących
Diety rozpisywane przez trenerów personalnych zawierają często błędy żywieniowe, a wśród nich zbyt niską kaloryczność, zbyt dużą zawartość węglowodanów oraz niewłaściwe źródła pokarmowe skupiające makroskładniki żywieniowe.
CBL przynosi wiele korzyści osobom rozpoczynającym przygodę ze sportem. Do najważniejszych z nich zaliczyć można m.in. poprawę zdrowia metabolicznego dzięki obniżeniu krążącej glukozy oraz insuliny, a także wzrost wrażliwości leptynowej, dzięki zredukowaniu ilości krążących trójglicerydów. Szczegóły w artykule Jakuba Mauricza i Michała Karmowskiego.
Metylacja i gen MTHFR stanowią temat artykułu Justyny Posłusznej.
Suplementacja selenu omówiona została przez Małgorzatę Ostrowską.
Zapraszamy do lektury!
- Ilona Otawska
- 30 października 2017
- Jakub Mauricz
- 30 października 2017
- Marek Fischer
- 30 października 2017
- Jakub Mauricz , Michał Karmowski
- 30 października 2017
- Małgorzata Ostrowska
- 30 października 2017
- Jan Paszkowski
- 30 października 2017
- Krystian Dziel
- 30 października 2017
- Honorata Dziel
- 30 października 2017
- Michał Undra
- 30 października 2017
- Justyna Posłuszna
- 30 października 2017
- Dominika Jankowska , Patrycja Szachta
- 30 października 2017
- Jakub Krzyżak
- 30 października 2017
- Paweł Głuchowski
- 30 października 2017
- Dawid Bukiel
- 30 października 2017
- Zuzanna Sobczak
- 30 października 2017
- Kamil Koczwara
- 30 października 2017
- Sebastian Gęsior
- 30 października 2017